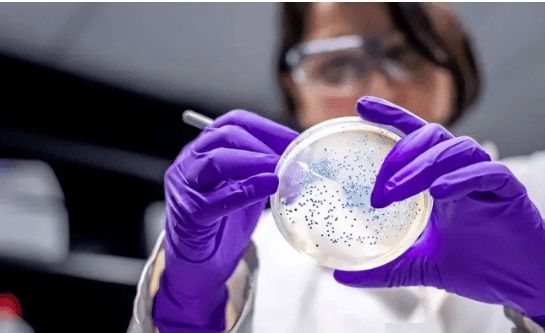

此前,中国出口的月饼、辣条等产品都曾因食品安全问题被国外召回,一时间,“中国制造=劣质产品”的标签似乎又要被贴上。

的确,随着生活水平的提高,人们对食品安全的容忍度越来越低,而那些抱着“赚快钱”心态的企业棋乐游戏凯发K8天生赢家一触即发。,最终只会“搬起石头砸自己的脚”。

据22日欧盟食品饲料类快速预警系统通报K8凯发(kaifa)官网,中国出口的蛋制品因为恩诺沙星超标,被紧急叫停,并且这批问题产品已经销往了欧洲十个国家,影响范围之广,令人震惊。

然而,这种药物在动物体内的残留会对人体健康造成潜在威胁,尤其是对儿童的危害更大棋乐游戏,可能导致耐药性问题,甚至引发“超级细菌”的出现。
调查显示K8凯发(kaifa)官网,长三角地区的孕妇和儿童尿液中均检测出了不同种类的抗生素,其中约80%的儿童尿液样本中查出了兽用抗生素成分棋乐游戏。

事实上,为了保障食品安全K8凯发(kaifa)官网,中国农业农村部早已制定了严格的兽药残留监控计划K8凯发引领业界,,要求对鸡蛋中的兽药残留成分进行严格管控。
然而棋乐游戏,上有政策,下有对策,在利益的驱使下,一些养殖户为了追求经济效益,不惜铤而走险,滥用抗生素,最终导致“毒鸡蛋”流入市场。

当时,随着中国改革开放的不断深入K8凯发(kaifa)官网,畜牧养殖业快速发展,为了追求更高的经济效益K8凯发(kaifa)官网,一些养殖户开始大量使用抗生素来预防和治疗动物疾病K8凯发(kaifa)官网。

一方面,抗生素的滥用会导致细菌产生耐药性,使得原本有效的抗生素失去作用,最终形成“超级细菌”,对人类健康构成严重威胁棋乐游戏。
另一方面,抗生素会通过食物链进入人体,对人体健康造成潜在危害,尤其是对儿童的生长发育和免疫系统造成不可逆转的损害。


复旦大学的研究团队曾对上海地区儿童尿液中的抗生素成分进行过长期监测,结果显示,从2017年到2020年凯发kaifa,,抗生素总检出率下降了近20%。

从养殖户到消费者,从监管部门到企业,都需要进一步加强对食品安全的重视,构建起一道坚不可摧的“防火墙”。

同时棋乐游戏K8凯发·娱乐旗舰(中国)天生赢家·一触即发,,要加强对养殖环节的监管,推广科学养殖技术,引导养殖户减少抗生素的使用,从源头上保障食品安全。
不能只顾眼前利益,要将食品安全放在首位,严格执行国家标准,建立健全食品安全追溯体系,让消费者买得放心,吃得安心K8凯发(kaifa)官网。


“毒鸡蛋”事件警示我们:食品安全没有捷径可走棋乐游戏K8凯发(kaifa)官网,只有付出百分之百的努力棋乐游戏,才能守护好“舌尖上的安全”k8凯发·20周年(中国)天生赢家·一触即发。
从“毒奶粉”到“毒鸡蛋”,一次次食品安全事件,不仅损害了消费者的健康,也重创了“中国制造”的形象。

只有政府、企业和消费者共同努力,才能重塑中国食品安全形象,让“中国制造”成为安全、优质的代名词。












